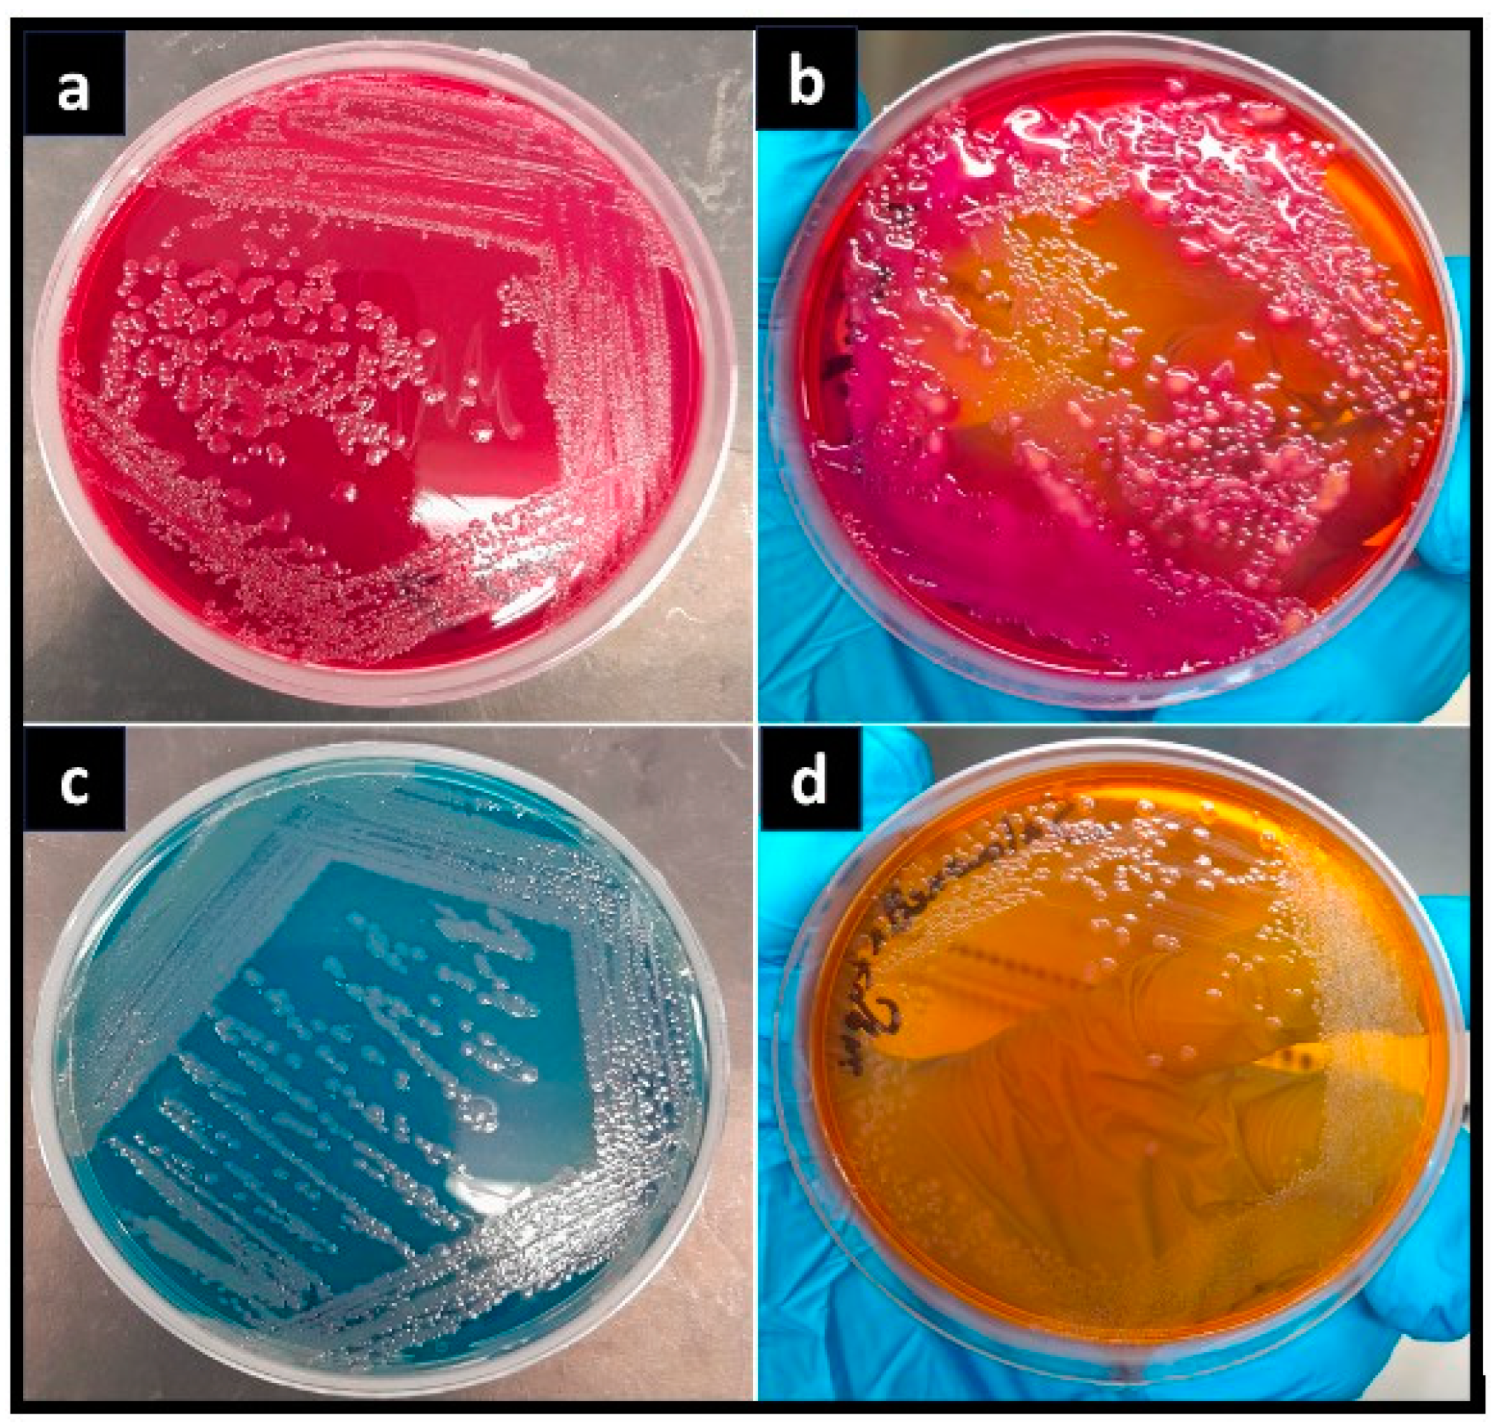
Pharmaceuticals 17 01546 g005
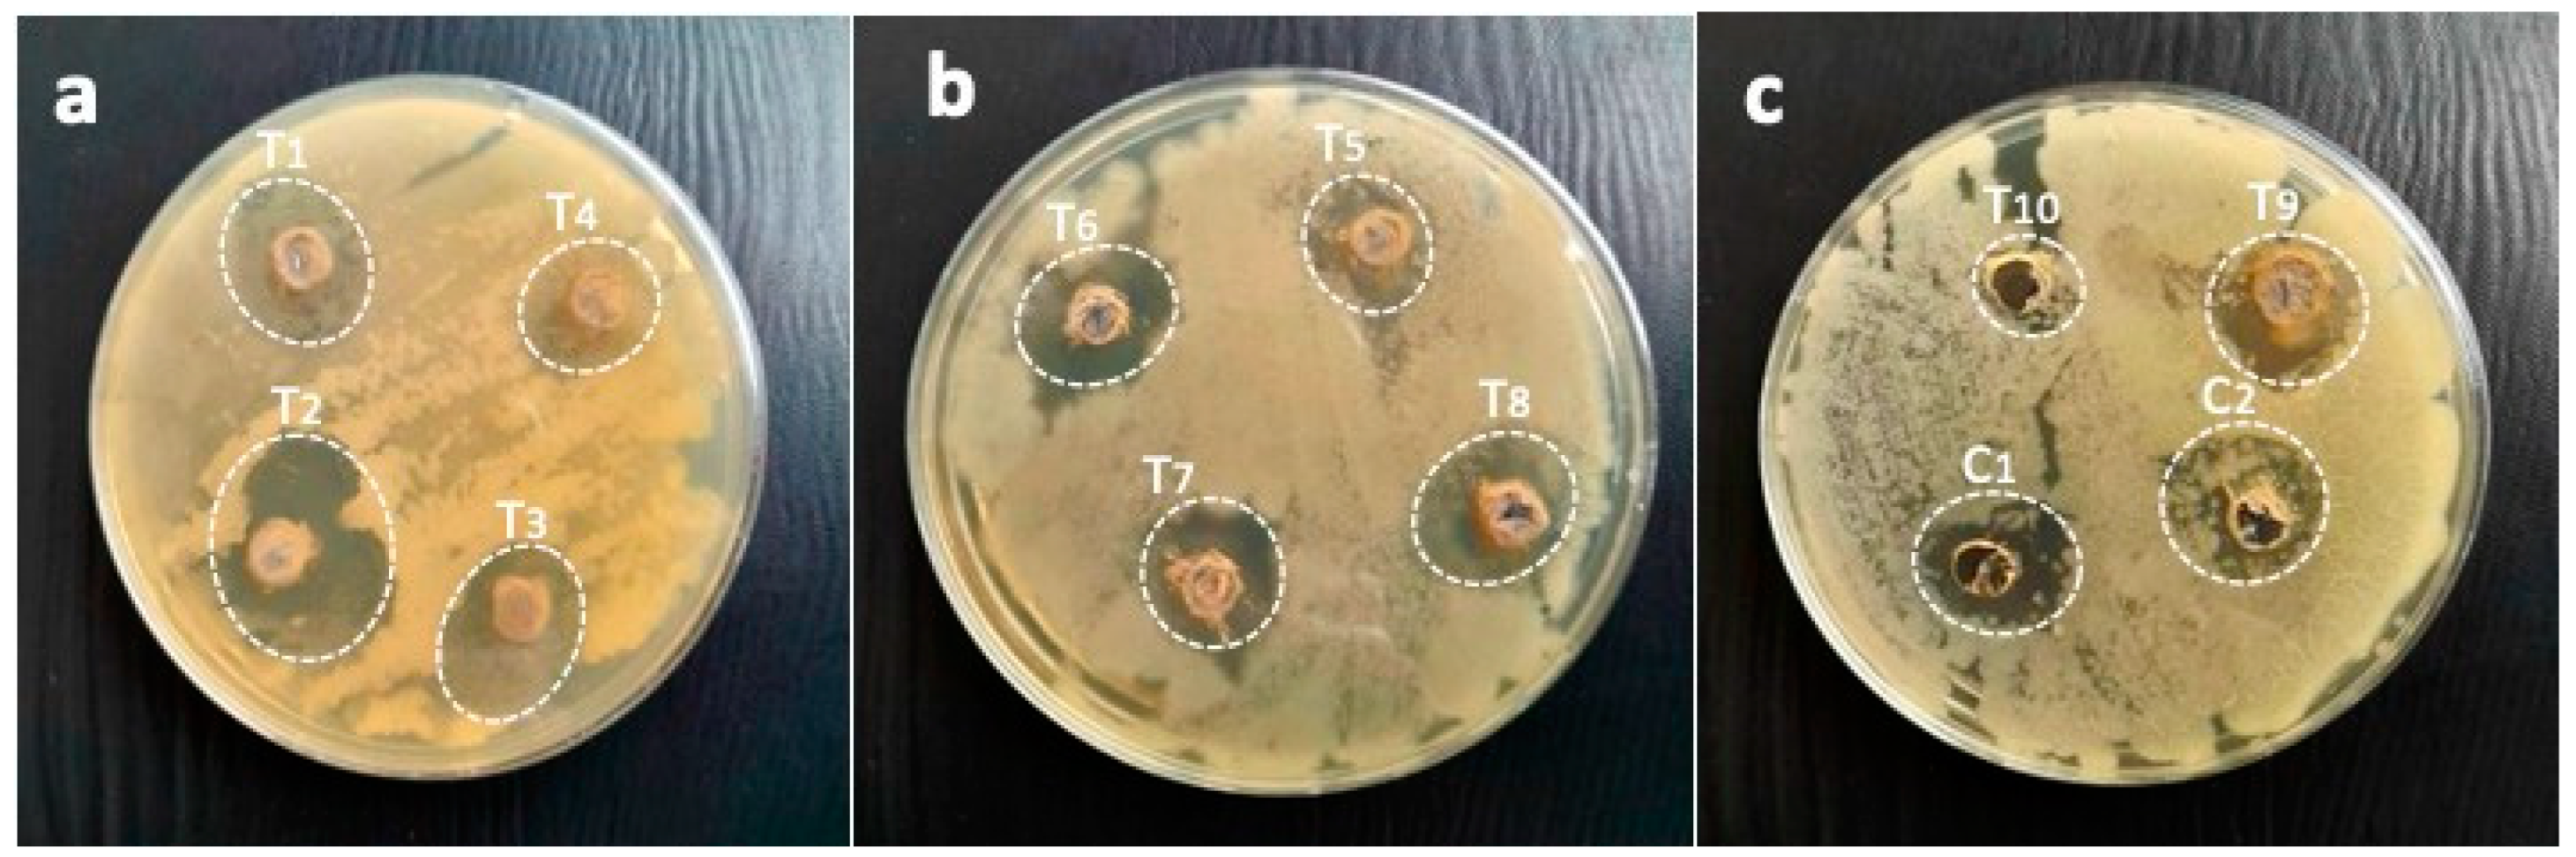
Pharmaceuticals 17 01546 g010
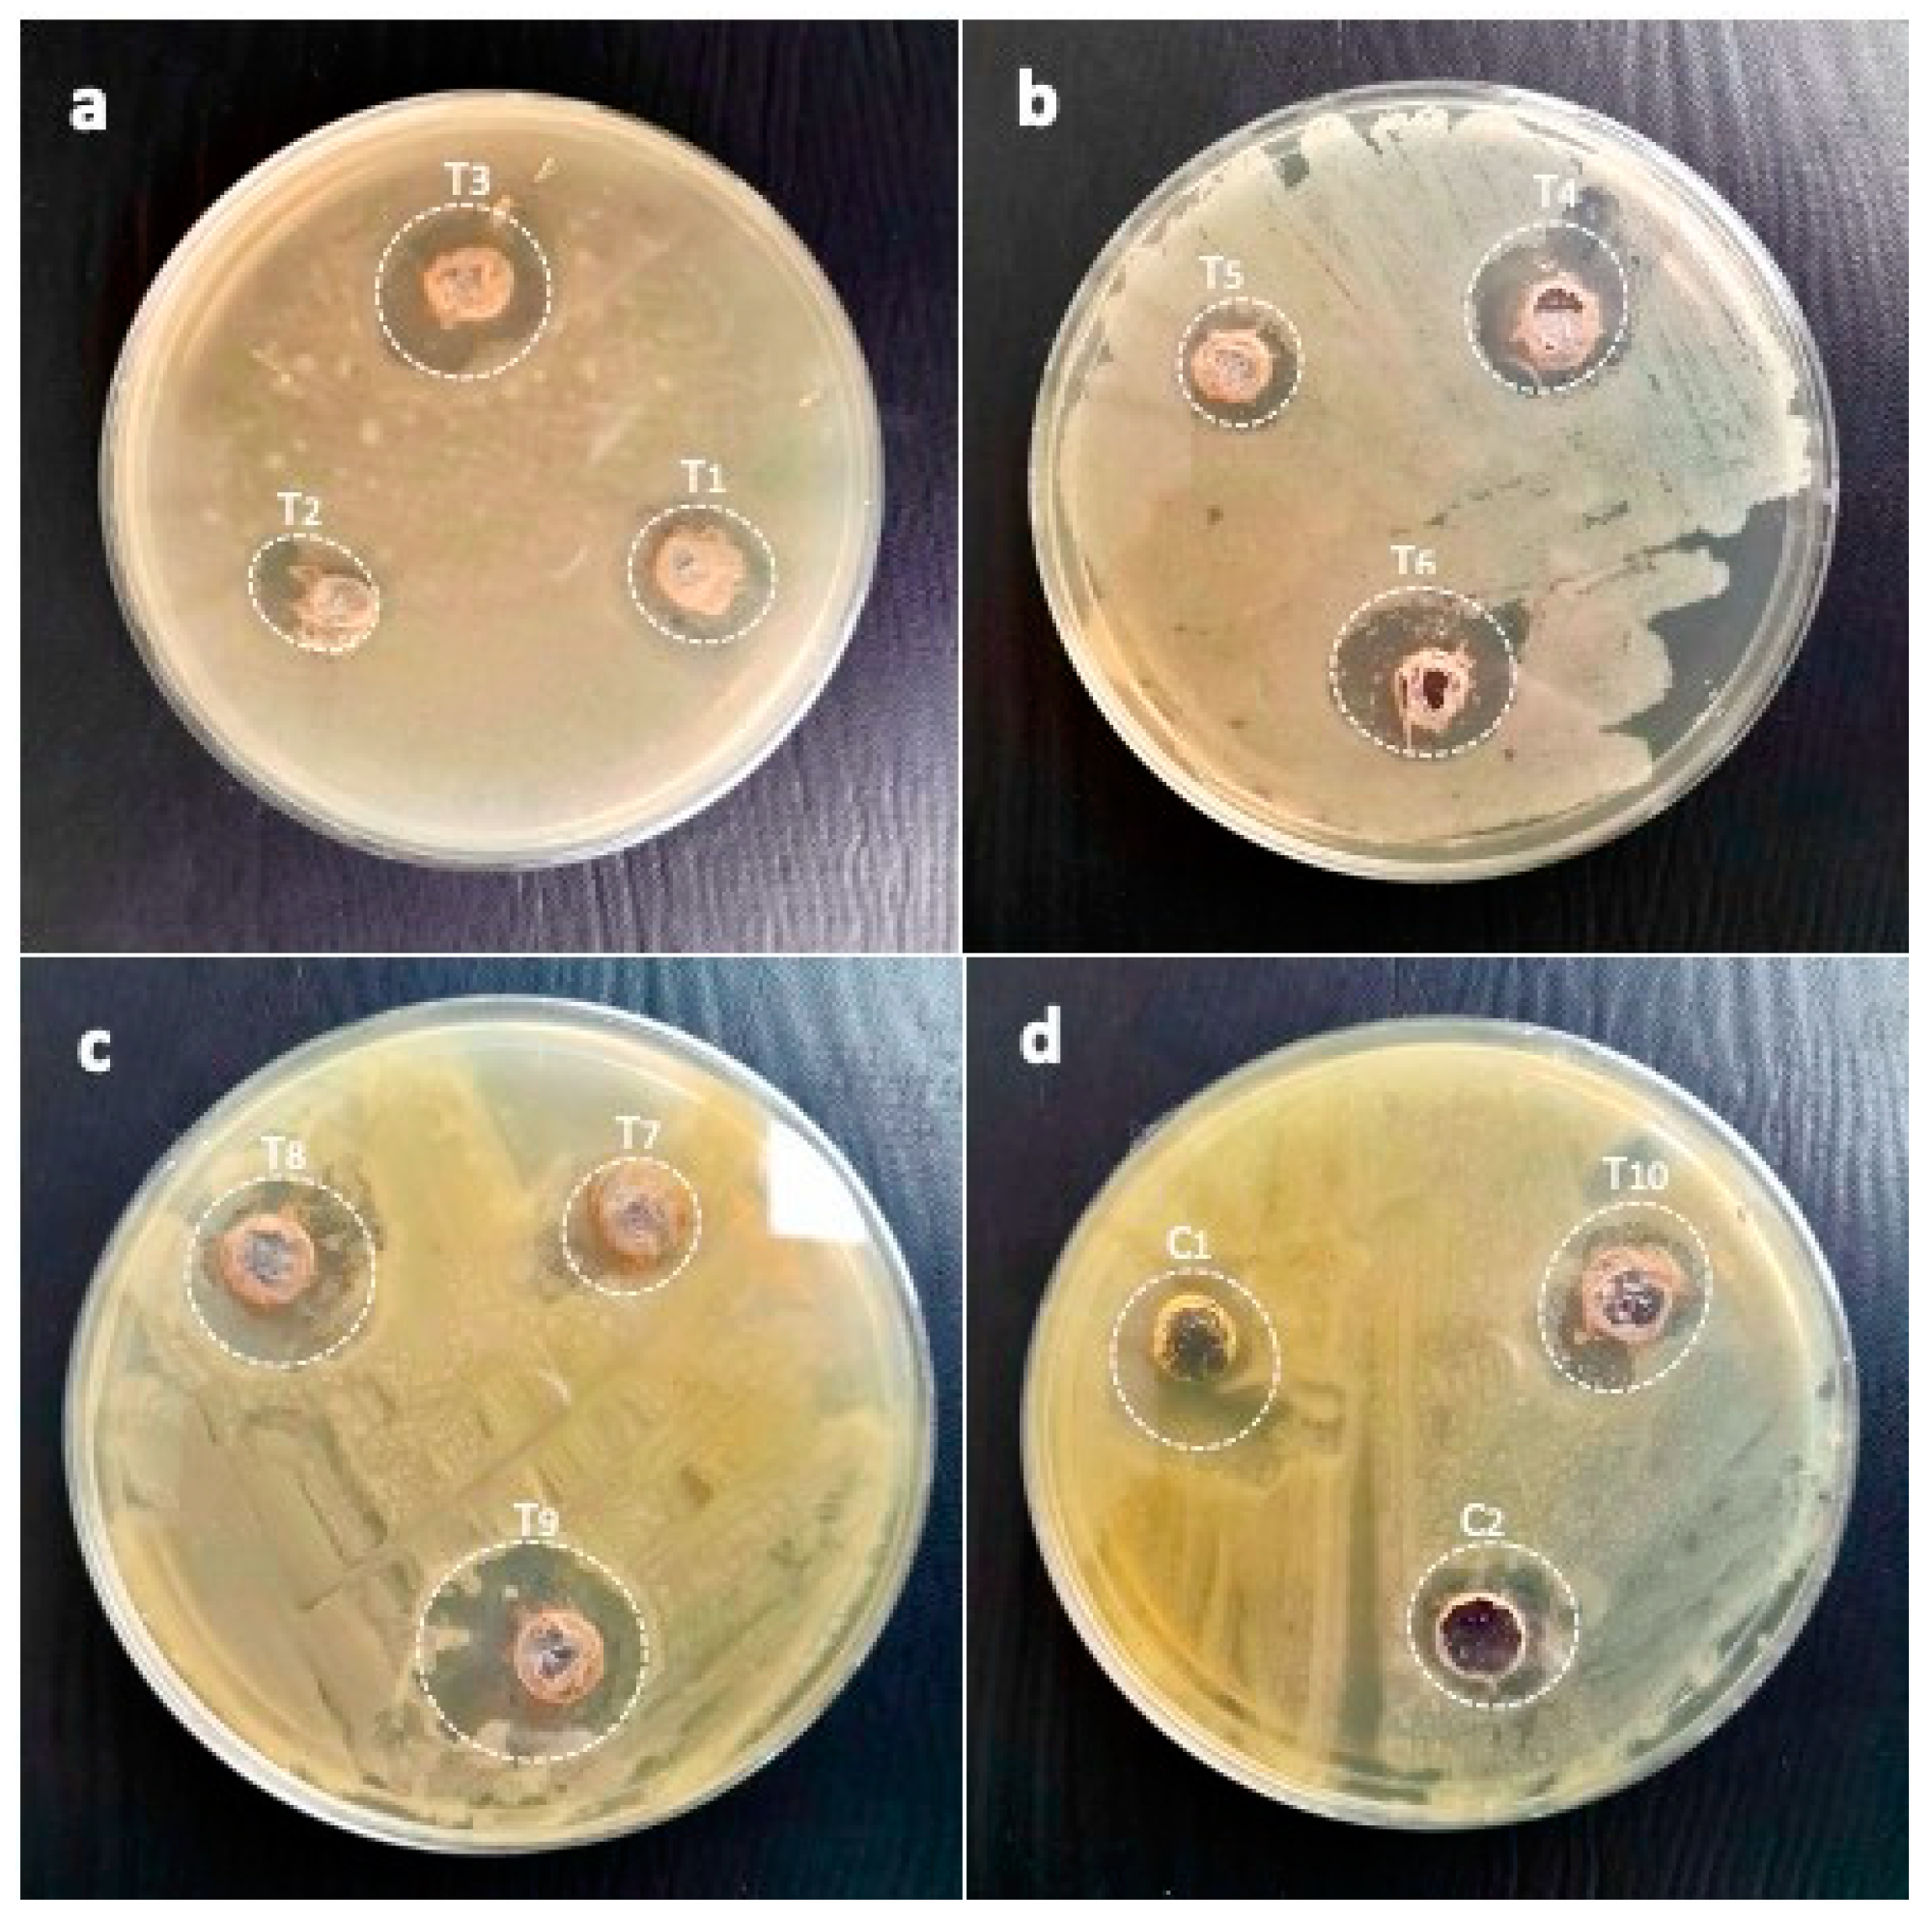
Pharmaceuticals 17 01546 g012
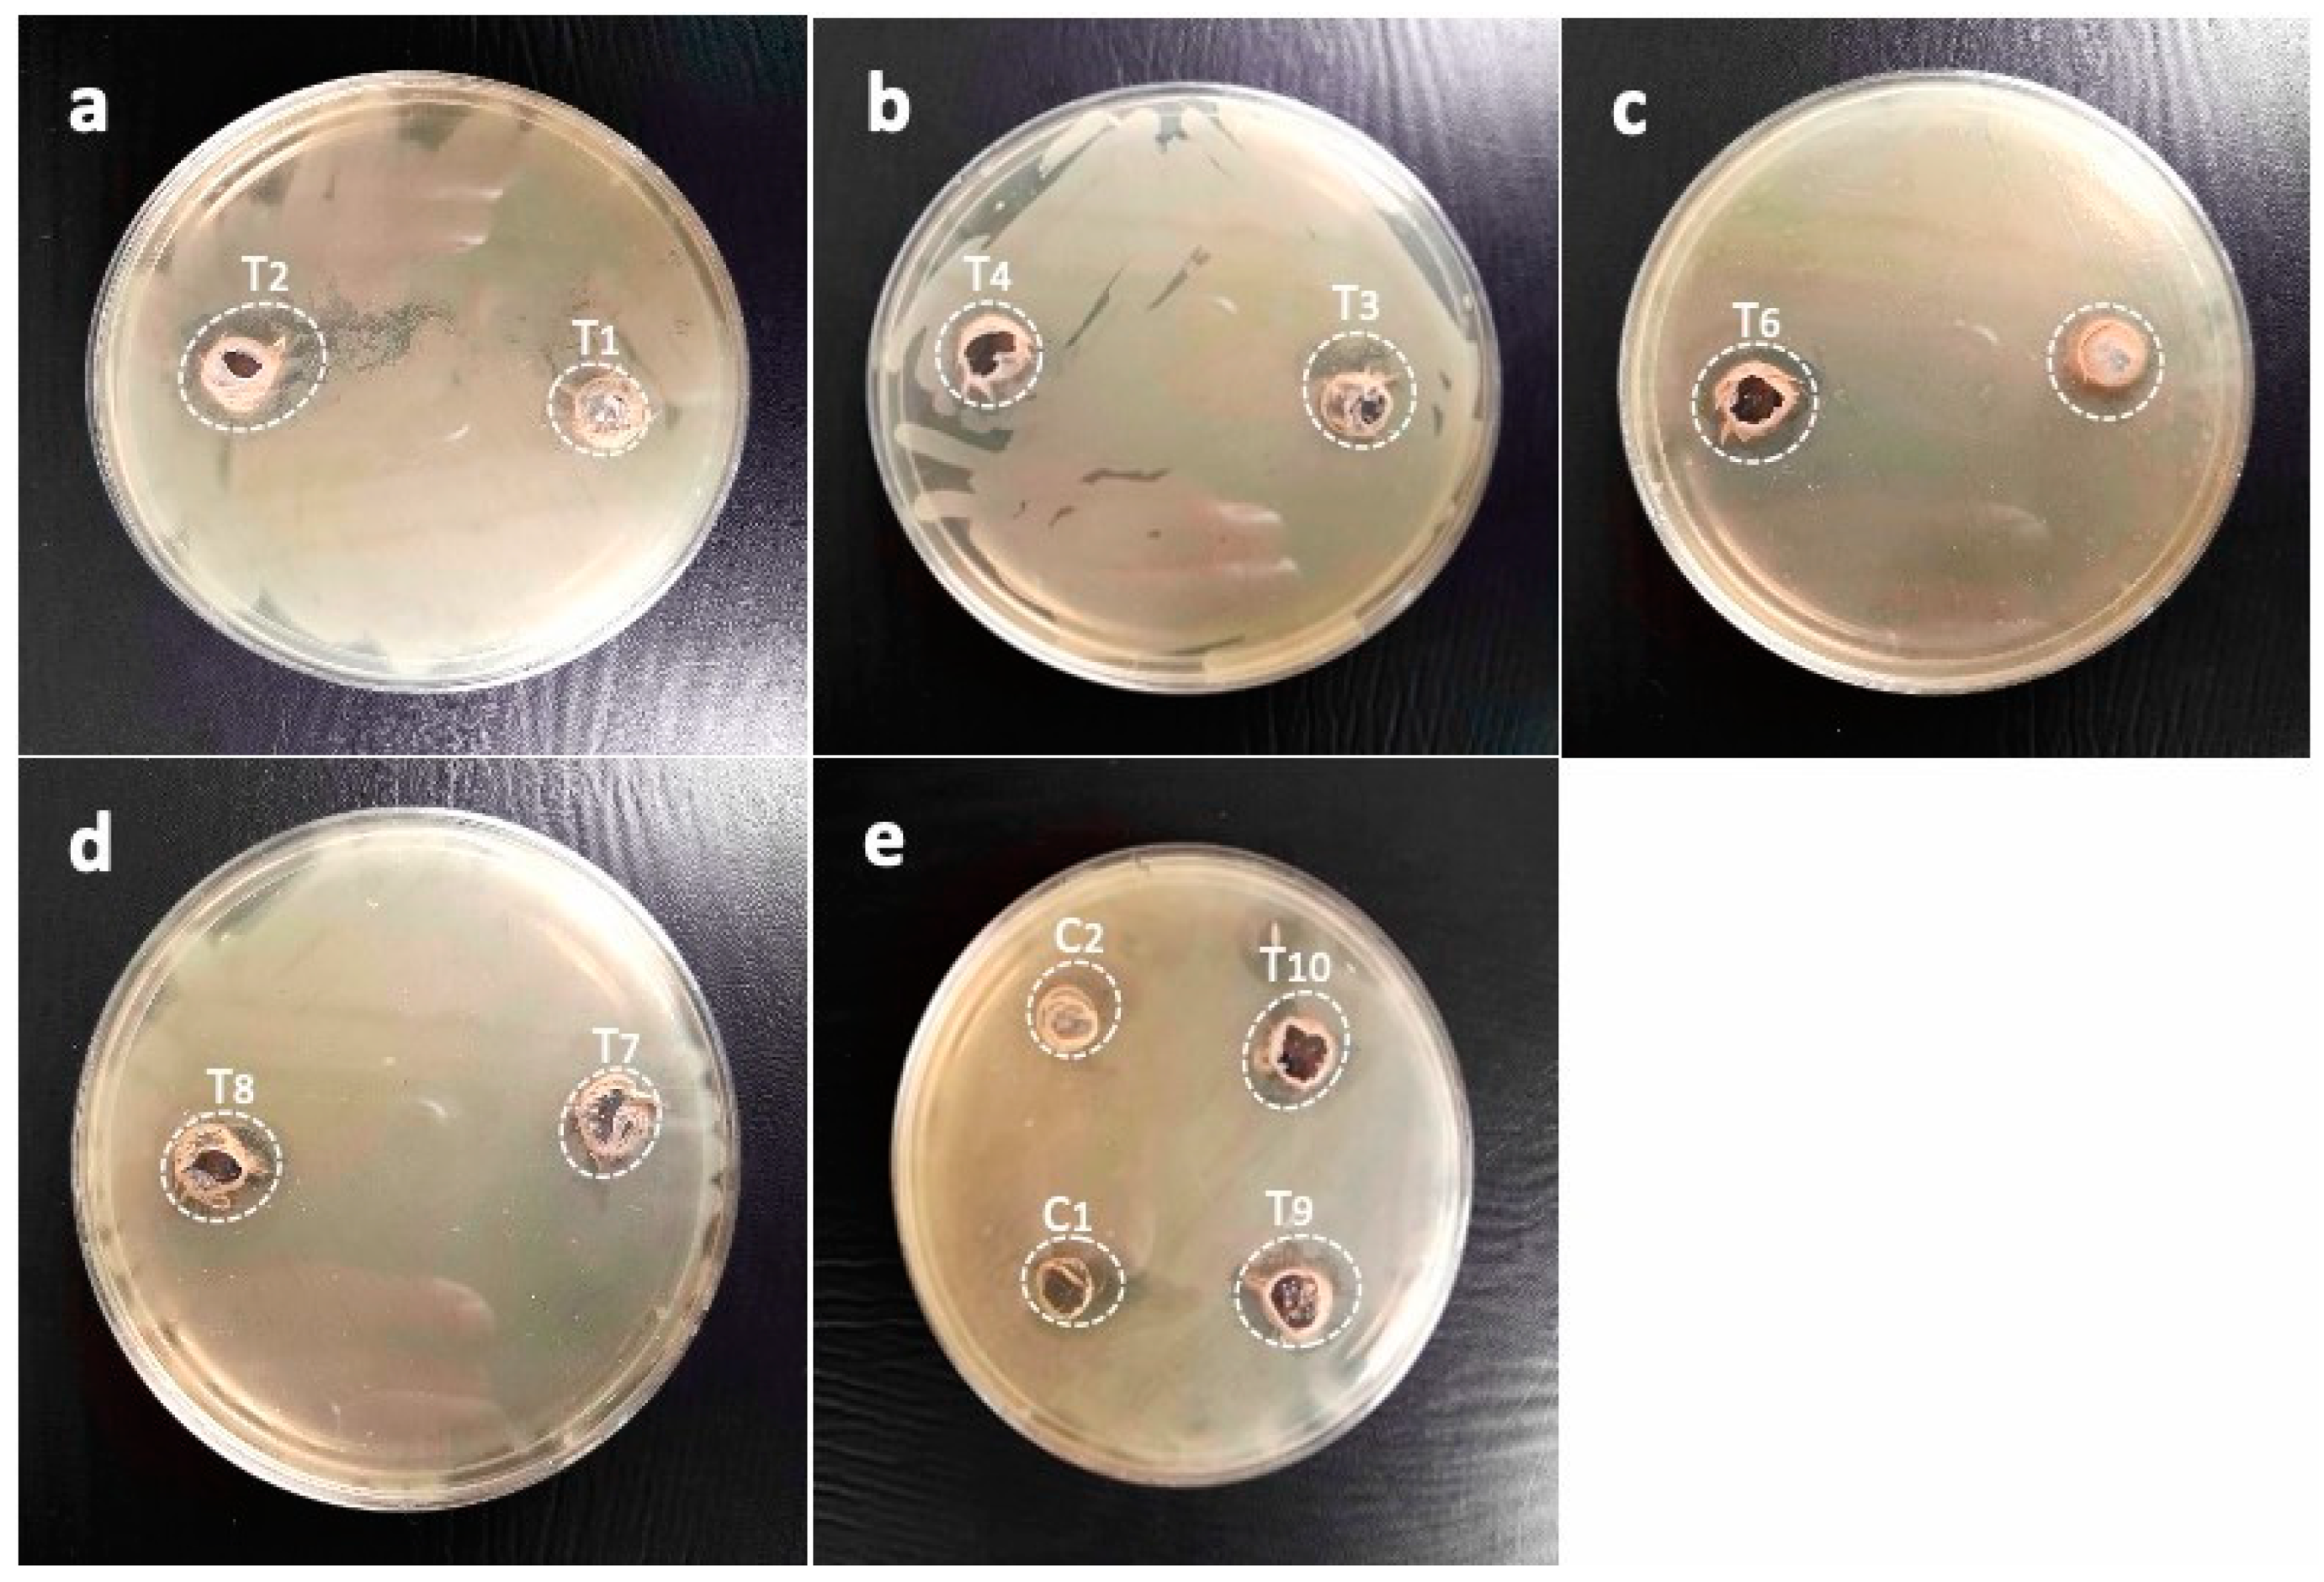
Pharmaceuticals 17 01546 g013
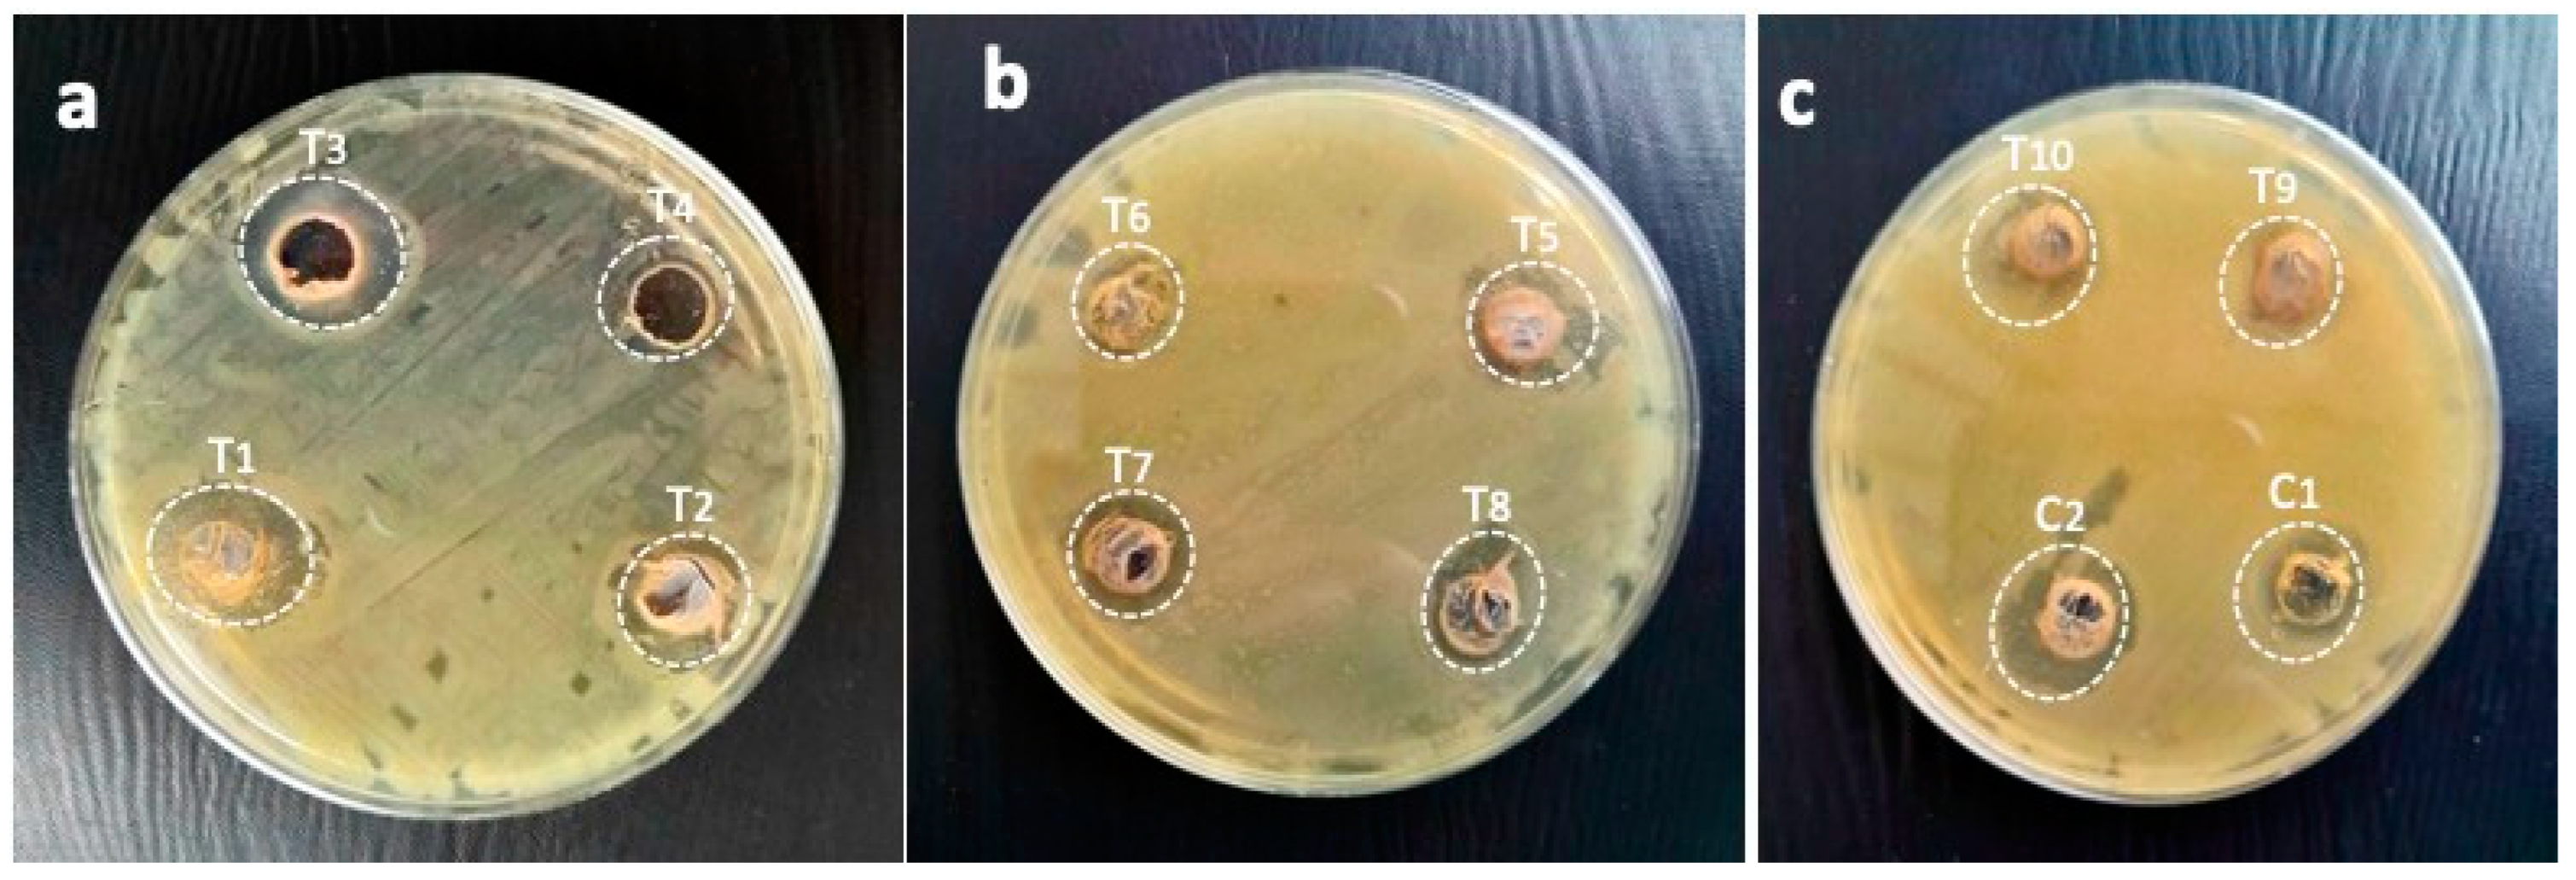
Pharmaceuticals 17 01546 g015

Immobilization of Silver Nanoparticles with Defensive Gum of Moringa oleifera for Antibacterial Efficacy Against Resistant Bacterial Species from Human Infections
Abstract
1. Introduction
2. Results
2.1. Biogenic Synthesis of Nanoparticles and Its Characterization
2.1.1. UV–Visible Spectrophotometry of Leaf-Derived AgNPs
2.1.2. Fourier Transform Infrared Spectroscopy (FTIR) ML-Derived AgNPs
2.1.3. X-Ray Diffraction Spectrum (XRD) Analysis of Biogenic AgNPs
2.1.4. Transmission Electron Microscopy of ML-Derived AgNPs
2.2. Morphological Identification of Bacterial Isolates
2.3. Identification Through Microscopy
2.4. Antibiotic Susceptibility Pattern
2.5. Antibacterial Potential of Immobilized AgNPs
2.6. Immobilized AgNP-Induced Growth Inhibition of Highly Resistant B. subtilis
2.7. Immobilized AgNP-Induced Growth Inhibition of Highly Resistant E. coli
2.8. Immobilized AgNP-Induced Inhibition of Highly Resistant K. pneumoniae
2.9. Immobilized AgNP-Induced Growth Inhibition of Highly Resistant P. mirabilis and the Zones of Inhibition of the Synergistic Combination of M. oleifera Gums
2.10. Immobilized AgNP-Induced Inhibition of Highly Resistant P. aeruginosa
2.11. Immobilized AgNP-Induced Growth Inhibition of S. typhi
3. Discussion
4. Materials and Methods
4.1. Collection of Plant Materials
4.2. Authentication of Plant Materials
4.3. Extract Preparation
4.4. Biogenic Synthesis of Silver Nanoparticles
4.5. Characterization of Silver Nanoparticles
4.5.1. UV–Spectrophotometry
4.5.2. Fourier Transform Infrared Spectroscopy (FTIR)
4.5.3. X-Ray Diffraction
4.5.4. TEM Analysis
4.6. Selection of Nanoparticles
4.7. Selection of Pathogens
4.8. Nutrient Agar Preparation
4.9. Antibiotic Susceptibility Test
4.10. Antimicrobial Assay of Immobilized AgNPs
4.11. Statistical Analysis
5. Conclusions
Supplementary Materials
Author Contributions
Funding
Institutional Review Board Statement
Informed Consent Statement
Data Availability Statement
Conflicts of Interest
References
- Fuglie, L.J. Producing Food Without Pesticides, Local Solutions to Crop Pest Control in West Africa; Church World Service, West Africa Office: Accra, Ghana, 1998. [Google Scholar]
- Abd Rani, N.Z.; Husain, K.; Kumolosasi, E. Moringa genus: A review of phytochemistry and pharmacology. Front. Pharmacol. 2018, 9, 108. [Google Scholar] [CrossRef]
- Edward, E. Survival, growth and biomass production of Moringa oleifera provenances at Gairo inland plateau and Ruvu Coastal Region in Tanzania. Afr. J. Plant Sci. 2014, 8, 54–64. [Google Scholar] [CrossRef]
- Jikah, A.N.; Edo, G.I. Moringa oleifera: A valuable insight into recent advances in medicinal uses and pharmacological activities. J. Sci. Food Agric. 2023, 103, 7343–7361. [Google Scholar] [CrossRef]
- Yerima, B.P.K.; Ayuk, G.M.; Enang, R.K.; Guehjung, N.; Tiamgne, Y.A. Germination and early seedling growth of Moringa oleifera Lam with different seeds soaking time and substrates at the Yongka Western Highlands Research Garden Park (YWHRGP) Nkwen-Bamenda, North-West Cameroon. Am. J. Plant Sci. 2016, 7, 2173–2185. [Google Scholar] [CrossRef]
- Kome, G.K.; Enang, R.K.; Tabi, F.O.; Yerima, B.P.K. Influence of clay minerals on some soil fertility attributes: A review. Open J. Soil. Sci. 2019, 9, 155–188. [Google Scholar] [CrossRef]
- Abd El-Hack, M.E.; Alagawany, M.; Elrys, A.S.; Desoky, E.S.M.; Tolba, H.M.; Elnahal, A.S.; Elnesr, S.S.; Swelum, A.A. Effect of forage Moringa oleifera L. (moringa) on animal health and nutrition and its beneficial applications in soil, plants and water purification. Agriculture 2018, 8, 145. [Google Scholar] [CrossRef]
- Mahmood, K.T.; Mugal, T.; Haq, I.U. Moringa oleifera: A natural gift-A review. J. Pharm. Sci. Res. 2010, 2, 775. [Google Scholar]
- Bhattacharya, A.; Ghosh, G.; Agrawal, D.; Sahu, P.K.; Kumar, S.; Mishra, S.S. GC-MS profiling of ethanolic extract of Moringa oleifera leaf. Int. J. Pharm. Bio Sci. 2014, 5, 263275. [Google Scholar]
- Faizi, S.; Siddiqui, B.S.; Saleem, R.; Siddiqui, S.; Aftab, K.; Gilani, A.U.H. Isolation and structure elucidation of new nitrile and mustard oil glycosides from Moringa oleifera and their effect on blood pressure. J. Nat. Prod. 1994, 57, 1256–1261. [Google Scholar] [CrossRef]
- Saini, R.K.; Shetty, N.P.; Giridhar, P. Carotenoid content in vegetative and reproductive parts of commercially grown Moringa oleifera Lam. cultivars from India by LC–APCI–MS. Eur. Food Res. Technol. 2014, 238, 971978. [Google Scholar] [CrossRef]
- Patel, S.; Thakur, A.S.; Chandy, A.; Manigauha, A. Moringa oleifera: A review of their medicinal and economical importance to the health and nation. Drug Invent. Today 2010, 2, 339–342. [Google Scholar]
- Guevara, A.P.; Vargas, C.; Sakurai, H.; Fujiwara, Y.; Hashimoto, K.; Maoka, T.; Kozuka, M.; Ito, Y.; Tokuda, H.; Nishino, H. An antitumor promoter from Moringa oleifera Lam. Mutat. Res./Genet. Toxicol. Environ. Mutagen. 1999, 440, 181–188. [Google Scholar] [CrossRef] [PubMed]
- Mohd Fisall, U.F.; Ismail, N.Z.; Adebayo, I.A.; Arsad, H. Dichloromethane fraction of Moringa oleifera leaf methanolic extract selectively inhibits breast cancer cells (MCF7) by induction of apoptosis via upregulation of Bax, p53 and caspase 8 expressions. Mol. Biol. Rep. 2021, 48, 4465–4475. [Google Scholar] [CrossRef]
- Upadhyay, P.; Yadav, M.K.; Mishra, S.; Sharma, P.; Purohit, S. Moringa oleifera: A review of the medical evidence for its nutritional and pharmacological properties. Int. J. Res. Pharm. Sci. 2015, 5, 12–16. [Google Scholar]
- Balogun, T.A.; Buliaminu, K.D.; Chukwudozie, O.S.; Tiamiyu, Z.A.; Idowu, T.J. Anticancer potential of Moringa oleifera on BRCA-1 gene: Systems biology. Bioinform. Biol. Insights 2021, 15, 11779322211010703. [Google Scholar] [CrossRef] [PubMed]
- Villarruel-López, A.; López-De La Mora, D.A.; Vázquez-Paulino, O.D.; Puebla-Mora, A.G.; Torres-Vitela, M.R.; Guerrero-Quiroz, L.A.; Nuño, K. Effect of Moringa oleifera consumption on diabetic rats. BMC Complement. Altern. Med. 2018, 18, 1–10. [Google Scholar] [CrossRef]
- Valle Jr, D.L.; Cabrera, E.C.; Puzon, J.J.M.; Rivera, W.L. Antimicrobial activities of methanol, ethanol and supercritical CO2 extracts of Philippine Piper betle L. on clinical isolates of gram positive and gram-negative bacteria with transferable multiple drug resistance. PLoS ONE 2016, 11, e0146349. [Google Scholar] [CrossRef]
- Moodley, J.S.; Krishna, S.B.N.; Pillay, K.; Sershen, F.; Govender, P. Green synthesis of silver nanoparticles from Moringa oleifera leaf extracts and its antimicrobial potential. Adv. Nat. Sci. Nanosci. Nanotechnol. 2018, 9, 015011. [Google Scholar] [CrossRef]
- Dalhoumi, W.; Guesmi, F.; Bouzidi, A.; Akermi, S.; Hfaiedh, N.; Saidi, I. Therapeutic strategies of Moringa oleifera Lam. (Moringaceae) for stomach and forestomach ulceration induced by HCl/EtOH in rat model. Saudi J. Biol. Sci. 2022, 29, 103284. [Google Scholar] [CrossRef]
- Singh, A.; Navneet, X. Ethnomedicinal, pharmacological and antimicrobial aspects of Moringa oleifera Lam. A review. J. Phytopharm. 2018, 7, 45–50. [Google Scholar] [CrossRef]
- Mishra, G.; Singh, P.; Verma, R.; Kumar, S.; Srivastav, S.; Jha, K.K.; Khosa, R.L. Traditional uses, phytochemistry and pharmacological properties of Moringa oleifera plant: An overview. Der Pharm. Lett. 2011, 3, 141–164. [Google Scholar]
- Vongsak, B.; Mangmool, S.; Gritsanapan, W. Antioxidant activity and induction of mRNA expressions of antioxidant enzymes in HEK-293 cells of Moringa oleifera leaf extract. Planta Medica 2015, 81, 1084–1089. [Google Scholar] [CrossRef] [PubMed]
- Okaiyeto, K.; Oguntibeju, O.O. African herbal medicines: Adverse effects and cytotoxic potentials with different therapeutic applications. Int. J. Environ. Res. Public Health 2021, 18, 5988. [Google Scholar] [CrossRef]
- Akinyede, K.A.; Ekpo, O.E.; Oguntibeju, O.O. Ethnopharmacology, therapeutic properties and nutritional potentials of Carpobrotus edulis: A comprehensive review. Sci. Pharm. 2020, 88, 39. [Google Scholar] [CrossRef]
- Adeyanju, A.A.; Oyenihi, O.R.; Oguntibeju, O.O. Antioxidant-Rich Vegetables: Impact on Human Health. In Vegetable CropsHealth Benefits and Cultivation; IntechOpen: London, UK, 2021. [Google Scholar]
- Attah, A.F.; Moody, J.O.; Sonibare, M.A.; Salahdeen, H.H.; Akindele, O.O.; Nnamani, P.O.; Diyaolu, O.A.; Raji, Y. Aqueous extract of Moringa oleifera leaf used in Nigerian ethnomedicine alters conception and some pregnancy outcomes in Wistar rat. S. Afr. J. Bot. 2020, 129, 255–262. [Google Scholar] [CrossRef]
- Bhattacharya, A.; Tiwari, P.; Sahu, P.K.; Kumar, S. A review of the phytochemical and pharmacological characteristics of Moringa oleifera. J. Pharm. Bioallied Sci. 2018, 10, 181. [Google Scholar]
- Ijioma, S.N.; Nwaogazi, E.N.; Nwankwo, A.A.; Oshilonya, H.; Ekeleme, C.M.; Oshilonya, L.U. Histological exhibition of the gastroprotective effect of Moringa oleifera leaf extract. Comp. Clin. Pathol. 2018, 27, 327–332. [Google Scholar] [CrossRef]
- Amrutia, J.N.; Lala, M.; Srinivasa, U.; Shabaraya, A.R.; Semuel, M.R. Anticonvulsant activity of Moringa oleifera leaf. Int. Res. J. Pharm. 2011, 2, 160–162. [Google Scholar]
- Panda, S.; Kar, A.; Sharma, P.; Sharma, A. Cardioprotective potential of N, α-l-rhamnopyranosyl vincosamide, an indole alkaloid, isolated from the leaves of Moringa oleifera in isoproterenol induced cardiotoxic rats: In vivo and in vitro studies. Bioorganic Med. Chem. Lett. 2013, 23, 959–962. [Google Scholar] [CrossRef]
- Salehi, B.; Quispe, C.; Sharifi-Rad, J.; Cruz-Martins, N.; Nigam, M.; Mishra, A.P.; Konovalov, D.A.; Orobinskaya, V.; Abu-Reidah, I.M.; Zam, W.; et al. Phytosterols: From preclinical evidence to potential clinical applications. Front. Pharmacol. 2021, 11, 1819. [Google Scholar] [CrossRef]
- Mbikay, M. Therapeutic potential of Moringa oleifera leaves in chronic hyperglycemia and dyslipidemia: A review. Front. Pharmacol. 2012, 3, 24. [Google Scholar] [CrossRef] [PubMed]
- Almatrafi, M.M.; Vergara-Jimenez, M.; Murillo, A.G.; Norris, G.H.; Blesso, C.N.; Fernandez, M.L. Moringa leaves prevent hepatic lipid accumulation and inflammation in guinea pigs by reducing the expression of genes involved in lipid metabolism. Int. J. Mol. Sci. 2017, 18, 1330. [Google Scholar] [CrossRef]
- Muhammad, A.A.; Arulselvan, P.; Cheah, P.S.; Abas, F.; Fakurazi, S. Evaluation of wound healing properties of bioactive aqueous fraction from Moringa oleifera Lam on experimentally induced diabetic animal model. Drug Des. Dev. Ther. 2016, 10, 1715–1730. [Google Scholar] [CrossRef] [PubMed]
- Awodele, O.; Oreagba, I.A.; Odoma, S.; da Silva, J.A.T.; Osunkalu, V.O. Toxicological evaluation of the aqueous leaf extract of Moringa oleifera Lam. (Moringaceae). J. Ethnopharmacol. 2012, 139, 330–336. [Google Scholar] [CrossRef]
- Anwar, F.; Latif, S.; Ashraf, M.; Gilani, A.H. Moringa oleifera: A food plant with multiple medicinal uses. Phytother. Res. An Int. J. Devoted Pharmacol. Toxicol. Eval. Nat. Product Deriv. 2007, 21, 17–25. [Google Scholar] [CrossRef] [PubMed]
- Sultana, B.; Anwar, E. Flavonols (kaempeferol, quercetin, myricetin) contents of selected fruits, vegetables and medicinal plants. Food Chem. 2008, 108, 879–884. [Google Scholar] [CrossRef] [PubMed]
- Islam, Z.; Islam, S.R.; Hossen, F.; Mahtab-ul-Islam, K.; Hasan, M.R.; Karim, R. Moringa oleifera is a prominent source of nutrients with potential health benefits. Int. J. Food Sci. 2021, 2021, 6627265. [Google Scholar] [CrossRef] [PubMed]
- Avachat, A.M.; Dash, R.R.; Shrotriya, S.N. Recent investigations of plant based natural gums, mucilages and resins in novel drug delivery systems. Ind. J. Pharm. Edu. Res. 2011, 45, 86–99. [Google Scholar]
- Amiri, M.S.; Mohammadzadeh, V.; Yazdi, M.E.T.; Barani, M.; Rahdar, A.; Kyzas, G.Z. Plant-based gums and mucilages applications in pharmacology and nanomedicine: A review. Molecules 2021, 26, 1770. [Google Scholar] [CrossRef]
- Amiri, M.S.; Yazdi, M.E.T.; Rahnama, M. Medicinal plants and phytotherapy in Iran: Glorious history, current status and future prospects. Plant Sci. Today 2021, 8, 95–111. [Google Scholar] [CrossRef]
- Nair, L.S.; Laurencin, C.T. Biodegradable polymers as biomaterials. Progr. Polym. Sci. 2007, 32, 762–798. [Google Scholar] [CrossRef]
- Zare, E.N.; Makvandi, P.; Borzacchiello, A.; Tay, F.R.; Ashtari, B.; Padil, V.V. Antimicrobial gum bio-based nanocomposites and their industrial and biomedical applications. Chem. Commun. 2019, 55, 14871–14885. [Google Scholar] [CrossRef]
- Mohammadzadeh, V.; Barani, M.; Amiri, M.S.; Yazdi, M.E.T.; Hassanisaadi, M.; Rahdar, A.; Varma, R.S. Applications of plant-based nanoparticles in nanomedicine: A review. Sustain. Chem. Pharm. 2022, 25, 100606. [Google Scholar] [CrossRef]
- Shukla, A.; Desai, K.; Modi, N. In vitro antioxidant and antimicrobial potential of Sterculia urens Roxb. root extract and its bioactive phytoconstituents evaluation. Future J. Pharm. Sci. 2020, 6, 1–11. [Google Scholar] [CrossRef]
- Yuan, L.; Wu, Y.; Qin, Y.; Yong, H.; Liu, J. Recent advances in the preparation, characterization and applications of locust bean gum-based films. J. Renew. Mater. 2020, 8, 1565–1579. [Google Scholar] [CrossRef]
- Rastogi, P.K.; Ganesan, V.; Krishnamoorthi, S. Microwave assisted polymer stabilized synthesis of silver nanoparticles and its application in the degradation of environmental pollutants. Mater. Sci. Eng. B 2012, 177, 456–461. [Google Scholar] [CrossRef]
- Costa, C.O.N.T.E.; Conte, A.; Buonocore, G.G.; Del Nobile, M.A. Antimicrobial silver-montmorillonite nanoparticles to prolong the shelf life of fresh fruit salad. Int. J. Food Microbiol. 2011, 148, 164–167. [Google Scholar] [CrossRef] [PubMed]
- De Moura, M.R.; Mattoso, L.H.; Zucolotto, V. Development of cellulose-based bactericidal nanocomposites containing silver nanoparticles and their use as active food packaging. J. Food Eng. 2012, 109, 520–524. [Google Scholar] [CrossRef]
- Haroon, M.; Zaidi, A.; Ahmed, B.; Rizvi, A.; Khan, M.S.; Musarrat, J. Effective inhibition of phytopathogenic microbes by eco-friendly leaf extract mediated silver nanoparticles (AgNPs). Indian J. Microbiol. 2019, 59, 273–287. [Google Scholar] [CrossRef]
- Jo, Y.K.; Seo, J.H.; Choi, B.H.; Kim, B.J.; Shin, H.H.; Hwang, B.H.; Cha, H.J. Surface-independent antibacterial coating using silver nanoparticle-generating engineered mussel glue. ACS Appl. Mater. Interfaces 2014, 6, 20242–20253. [Google Scholar] [CrossRef]
- Zhao, L.; Chu, P.K.; Zhang, Y.; Wu, Z. Antibacterial coatings on titanium implants. J. Biomed. Mater. Res. Part B Appl. Biomater. 2009, 91, 470–480. [Google Scholar] [CrossRef] [PubMed]
- Rai, M.; Yadav, A.; Gade, A. Silver nanoparticles as a new generation of antimicrobials. Biotechnol. Adv. 2009, 27, 76–83. [Google Scholar] [CrossRef] [PubMed]
- Arakawa, Y.; Wiesner, M.; Wennemers, H. Efficient recovery and reuse of an immobilized peptidic organocatalyst. Adv. Synth. Catal. 2011, 353, 1201–1206. [Google Scholar] [CrossRef]
- Mateo, C.; Palomo, J.M.; Fernandez-Lorente, G.; Guisan, J.M.; Fernandez-Lafuente, R. Improvement of enzyme activity, stability and selectivity via immobilization techniques. Enzym. Microb. Technol. 2007, 40, 1451–1463. [Google Scholar] [CrossRef]
- Tischer, W.; Wedekind, F. Immobilized enzymes: Methods and applications. In Biocatalysis-from Discovery to Application; Springer: Berlin/Heidelberg, Germany, 1999; pp. 95–126. [Google Scholar]
- Miletić, N.; Nastasović, A.; Loos, K. Immobilization of biocatalysts for enzymatic polymerizations: Possibilities, advantages, applications. Bioresour. Technol. 2012, 115, 126–135. [Google Scholar] [CrossRef]
- Yang, Z.; Castrignanò, E.; Estrela, P.; Frost, C.G.; Kasprzyk-Hordern, B. Community sewage sensors towards evaluation of drug use trends: Detection of cocaine in wastewater with DNA-directed immobilization aptamer sensors. Sci. Rep. 2016, 6, 21024. [Google Scholar] [CrossRef] [PubMed]
- Balamurugan, S.; Obubuafo, A.; Soper, S.A.; Spivak, D.A. Surface immobilization methods for aptamer diagnostic applications. Anal. Bioanal. Chem. 2008, 390, 1009–1021. [Google Scholar] [CrossRef]
- Wu, C.; Zhi, D.; Yao, B.; Zhou, Y.; Yang, Y.; Zhou, Y. Immobilization of microbes on biochar for water and soil remediation: A review. Environ. Res. 2022, 212, 113226. [Google Scholar] [CrossRef]
- Huang, L.; Zhao, S.; Wang, Z.; Wu, J.; Wang, J.; Wang, S. In situ immobilization of silver nanoparticles for improving permeability, antifouling and anti-bacterial properties of ultrafiltration membrane. J. Membr. Sci. 2016, 499, 269–281. [Google Scholar] [CrossRef]
- GhavamiNejad, A.; Aguilar, L.E.; Ambade, R.B.; Lee, S.H.; Park, C.H.; Kim, C.S. Immobilization of silver nanoparticles on electropolymerized polydopamine films for metal implant applications. Colloids Interface Sci. Commun. 2015, 6, 5–8. [Google Scholar] [CrossRef]
- Mallikharjuna, P.B.; Rajanna, L.N.; Seetharam, Y.N.; Sharanabasappa, G.K. Phytochemical studies of Strychnos potatorum Lf-A medicinal plant. J. Chem. 2007, 4, 510–518. [Google Scholar] [CrossRef]
- Carnachan, S.M.; Bell, T.J.; Hinkley, S.F.; Sims, I.M. Polysaccharides from New Zealand native plants: A review of their structure, properties, and potential applications. Plants 2019, 8, 163. [Google Scholar] [CrossRef]
- Medina, E.; Pieper, D.H. Tackling threats and future problems of multidrug-resistant bacteria. In How to Overcome the Antibiotic Crisis: Facts, Challenges, Technologies and Future Perspectives; Springer: Cham, Switzerland, 2016; pp. 3–33. [Google Scholar]
- Baptista, P.V.; McCusker, M.P.; Carvalho, A.; Ferreira, D.A.; Mohan, N.M.; Martins, M.; Fernandes, A.R. Nano-strategies to fight multidrug resistant bacteria—“A Battle of the Titans”. Front. Microbiol. 2018, 9, 1441. [Google Scholar] [CrossRef] [PubMed]
- Maniraj, A.; Kannan, M.; Rajarathinam, K.; Vivekanandhan, S.; Muthuramkumar, S. Green synthesis of silver nanoparticles and their effective utilization in fabricating functional surface for antibacterial activity against multi-drug resistant Proteus mirabilis. J. Clust. Sci. 2019, 30, 1403–1414. [Google Scholar] [CrossRef]
- Thomas, R.; Nair, A.P.; Kr, S.; Mathew, J.; Ek, R. Antibacterial activity and synergistic effect of biosynthesized AgNPs with antibiotics against multidrugresistant biofilm-forming coagulase-negative staphylococci isolated from clinical samples. Appl. Biochem. Biotechnol. 2014, 173, 449–460. [Google Scholar] [CrossRef]
- Chandrashekar, S.; Vijayakumar, R.; Chelliah, R.; Oh, D.H. Identification and purification of potential bioactive peptide of Moringa oleifera seed extracts. Plants 2020, 9, 1445. [Google Scholar] [CrossRef] [PubMed]
- Bapat, R.A.; Chaubal, T.V.; Joshi, C.P.; Bapat, P.R.; Choudhury, H.; Pandey, M.; Gorain, B.; Kesharwani, P. An overview of application of silver nanoparticles for biomaterials in dentistry. Mater. Sci. Eng. C 2018, 91, 881–898. [Google Scholar] [CrossRef]
- Klueh, U.; Wagner, V.; Kelly, S.; Johnson, A.; Bryers, J.D. Efficacy of silver coated fabric to prevent bacterial colonization and subsequent device based biofilm formation. J. Biomed. Mater. Res. Off. J. Soc. Biomater. Jpn. Soc. Biomater. Aust. Soc. Biomater. Korean Soc. Biomater. 2000, 53, 621–631. [Google Scholar] [CrossRef]
- Yakabe, Y.; Sano, T.; Ushio, H.; Yasunaga, T. Kinetic studies of the interaction between silver ion and deoxyribonucleic acid. Chem. Lett. 1980, 9, 373–376. [Google Scholar] [CrossRef]
- Chouhan, S.; Guleria, S. Green synthesis of AgNPs using Cannabis sativa leaf extract: Characterization, antibacterial, antiyeast and α-amylase inhibitory activity. Mater. Sci. Energy Technol. 2020, 3, 536–544. [Google Scholar] [CrossRef]
- Cao, R.J.; Mirkin, C.A. DNA-modified core− shell Ag/Au nanoparticles. J. Am. Chem. Soc. 2001, 123, 7961–7962. [Google Scholar] [CrossRef] [PubMed]
- Wright, J.B.; Lam, K.; Hansen, D.; Burrell, R.E. Efficacy of topical silver against fungal burn wound pathogens. Am. J. Infect. Control 1999, 27, 344–350. [Google Scholar] [CrossRef] [PubMed]
- Khorrami, S.; Zarrabi, A.; Khaleghi, M.; Danaei, M.; Mozafari, M.R. Selective cytotoxicity of green synthesized silver nanoparticles against the MCF-7 tumor cell line and their enhanced antioxidant and antimicrobial properties. Int. J. Nanomed. 2018, 13, 8013–8024. [Google Scholar] [CrossRef]
- Das, S.S.; Alkahtani, S.; Bharadwaj, P.; Ansari, M.T.; ALKahtani, M.D.; Pang, Z.; Hasnain, M.S.; Nayak, A.K.; Aminabhavi, T.M. Molecular insights and novel approaches for targeting tumor metastasis. Int. J. Pharm. 2020, 585, 119556. [Google Scholar] [CrossRef] [PubMed]
- Pareek, V.; Gupta, R.; Panwar, J. Do physico-chemical properties of silver nanoparticles decide their interaction with biological media and bactericidal action? A review. Mater. Sci. Eng. C 2018, 90, 739–749. [Google Scholar] [CrossRef]
- Ahmad, S.A.; Das, S.S.; Khatoon, A.; Ansari, M.T.; Afzal, M.; Hasnain, M.S.; Nayak, A.K. Bactericidal activity of silver nanoparticles: A mechanistic review. Mater. Sci. Energy Technol. 2020, 3, 756–769. [Google Scholar] [CrossRef]
- Khan, A.; Ahmad, N.; Fazal, H.; Ali, M.; Akbar, F.; Khan, I.; Tayyab, M.; Uddin, M.N.; Ahmad, N.; Abdel-Maksoud, M.A.; et al. Biogenic synthesis of silver nanoparticles using Rubus fruticosus extract and their antibacterial efficacy against Erwinia caratovora and Ralstonia solanacearum phytopathogens. RSC Adv. 2024, 14, 5754–5763. [Google Scholar] [CrossRef]
- Ali, M.; Kim, B.; Belfield, K.D.; Norman, D.; Brennan, M.; Ali, G.S. Green synthesis and characterization of silver nanoparticles using Artemisia absinthium aqueous extract—A comprehensive study. Mater. Sci. Eng. C 2016, 58, 359–365. [Google Scholar] [CrossRef]
- Li, X.; Wang, Y.; Huang, D.; Jiang, Z.; He, Z.; Luo, M.; Lei, J.; Xiao, Y. Nanomaterials Modulating the Fate of Dental-Derived Mesenchymal Stem Cells Involved in Oral Tissue Reconstruction: A Systematic Review. Int. J. Nanomed. 2023, 18, 5377–5406. [Google Scholar] [CrossRef]
- Singh, A.; Agrawal, M.; Marshall, F.M. The role of organic vs. inorganic fertilizers in reducing phytoavailability of heavy metals in a wastewater-irrigated area. Ecol. Eng. 2010, 36, 1733–1740. [Google Scholar] [CrossRef]
- Kato, A.; Yoshifuji, A.; Komori, K.; Aoki, K.; Taniyama, D.; Komatsu, M.; Fujii, K.; Yamada, K.; Ishii, Y.; Kikuchi, T.; et al. A case of Bacillus subtilis var. natto bacteremia caused by ingestion of natto during COVID-19 treatment in a maintenance hemodialysis patient with multiple myeloma. J. Infect. Chemother. 2022, 28, 1212–1215. [Google Scholar] [CrossRef] [PubMed]
- Cabrera-Sosa, L.; Ochoa, T.J. Escherichia coli diarrhea. In Hunter’s Tropical Medicine and Emerging Infectious Diseases; Elsevier: Amsterdam, The Netherlands, 2020; pp. 481–485. [Google Scholar] [CrossRef]
- Gupta, A. Hospital-acquired infections in the neonatal intensive care unit-Klebsiella pneumoniae. In Seminars in Perinatology; Elsevier: Amsterdam, The Netherlands, 2002. [Google Scholar] [CrossRef]
- Jacobsen, S.M.; Stickler, D.J.; Mobley, H.L.; Shirtliff, M.E. Complicated catheter-associated urinary tract infections due to Escherichia coli and Proteus mirabilis. Clin. Microbiol. Rev. 2008, 21, 26–59. [Google Scholar] [CrossRef] [PubMed]
- Arancibia, F.; Bauer, T.T.; Ewig, S.; Mensa, J.; Gonzalez, J.; Niederman, M.S.; Torres, A. Community-acquired pneumonia due to gram-negative bacteria and Pseudomonas aeruginosa: Incidence, risk, and prognosis. Arch. Intern. Med. 2002, 162, 1849–1858. [Google Scholar] [CrossRef]
- Raffatellu, M.; Wilson, R.P.; Winter, S.E.; Baumler, A.J. Clinical pathogenesis of typhoid fever. J. Infect. Dev. Ctries 2008, 2, 260–266. [Google Scholar] [CrossRef] [PubMed]
- Fazal, H.I.N.A.; Ahmad, N.; Ullah, I.; Inayat, H.; Khan, L.; Abbasi, B.H. Antibacterial potential in Parthenium hysterophorus, Stevia rebaudiana and Ginkgo biloba. Pak. J. Bot. 2011, 43, 1307–1313. [Google Scholar]
- Merchant, I.A. Veterinary Bacteriology and Virology, 4th ed.; Iowa State College Press, the University of California: Ames, IA, USA, 1950. [Google Scholar]
- Ahmad, N.; Ali, S.; Abbas, M.; Fazal, H.; Saqib, S.; Ali, A.; Ullah, Z.; Zaman, S.; Sawati, L.; Zada, A. Sohail, Antimicrobial efficacy of Mentha piperata-derived biogenic zinc oxide nanoparticles against UTI-resistant pathogens. Sci. Rep. 2023, 13, 14972. [Google Scholar] [CrossRef]
- Ahmad, N.; Muhammad, J.; Khan, K.; Ali, W.; Fazal, H.; Ali, M.; Rahman, L.U.; Khan, H.; Uddin, M.N.; Abbasi, B.H.; et al. Silver and gold nanoparticles induced differential antimicrobial potential in calli cultures of Prunella vulgaris. BMC Chem. 2022, 16, 20. [Google Scholar] [CrossRef]

| Pathogenic Species | Zones of Inhibition (mm) of Different Antibiotics | |||||||
|---|---|---|---|---|---|---|---|---|
| Do | CRO | CTX | SCF | E | SXT | IPM | AZM | |
| B. subtilis | 10.1 ± 0.1 | 12.2 ± 0.4 | 15.3 ± 0.3 | 17.3 ± 0.3 | R | R | --- | R |
| E. coli | 8.3 ± 0.1 | 10.2 ± 0.1 | 13.5 ± 0.4 | R | R | 14.6 ± 0.5 | 15.1 ± 0.3 | R |
| K. pneumoniae | 10.5 ± 0.2 | R | 10.6 ± 0.6 | 17.3 ± 0.3 | R | R | 15.4 ± 0.7 | 10.2 ± 0.4 |
| P. aeruginosa | 8.9 ± 0.2 | R | R | R | R | R | 10.2 ± 0.8 | R |
| P. mirabilis | 18.2 ± 0.4 | R | 10.3 ± 0.1 | 18.4 ± 0.6 | --- | R | 12.4 ± 0.2 | R |
| S. typhi | 14.3 ± 0.1 | R | 10.2 ± 0.3 | 15.2 ± 0.5 | --- | R | 12.3 ± 0.5 | R |
| Voucher Specimen Numbers | Bacterial Strain | Types | Source |
|---|---|---|---|
| MBC-MIC-208 | B. subtilis | G + ve | PCSIR Peshawar |
| MBC-MIC-003 | E. coli | G − ve | PCSIR Peshawar |
| MBC-MIC-459 | K. pneumoniae | G − ve | PCSIR Peshawar |
| MBC-MIC-405 | P. mirabilis | G − ve | PCSIR Peshawar |
| MBC-MIC-051 | P. aeruginosa | G − ve | PCSIR Peshawar |
| MBC-MIC-104 | S. typhi | G − ve | PCSIR Peshawar |
| Treatments | Applied Combinations |
|---|---|
| T1 | 25 µL AgNPs + 200 µL gums |
| T2 | 50 µL AgNPs + 200 µL gums |
| T3 | 75 µL AgNPs + 200 µL gums |
| T4 | 100 µL AgNPs + 200 µL gums |
| T5 | 125 µL AgNPs + 200 µL gums |
| T6 | 150 µL AgNPs + 200 µL gums |
| T7 | 175 µL AgNPs + 200 µL gums |
| T8 | 200 µL AgNPs + 200 µL gums |
| T9 | 225 µL AgNPs + 200 µL gums |
| T10 | 250 µL AgNPs + 200 µL gums |
| C1 | 100 µL AgNPs alone |
| C2 | 200 µL gums alone |
Disclaimer/Publisher’s Note: The statements, opinions and data contained in all publications are solely those of the individual author(s) and contributor(s) and not of MDPI and/or the editor(s). MDPI and/or the editor(s) disclaim responsibility for any injury to people or property resulting from any ideas, methods, instructions or products referred to in the content. |
© 2024 by the authors. Licensee MDPI, Basel, Switzerland. This article is an open access article distributed under the terms and conditions of the Creative Commons Attribution (CC BY) license (https://creativecommons.org/licenses/by/4.0/).
Share and Cite
Ali, L.; Ahmad, N.; Uddin, M.N.; Abdel-Maksoud, M.A.; Fazal, H.; Fatima, S.; El-Tayeb, M.A.; Kiani, B.H.; Khan, W.; Rahat, M.A.; et al. Immobilization of Silver Nanoparticles with Defensive Gum of Moringa oleifera for Antibacterial Efficacy Against Resistant Bacterial Species from Human Infections. Pharmaceuticals 2024, 17, 1546. https://doi.org/10.3390/ph17111546
Ali L, Ahmad N, Uddin MN, Abdel-Maksoud MA, Fazal H, Fatima S, El-Tayeb MA, Kiani BH, Khan W, Rahat MA, et al. Immobilization of Silver Nanoparticles with Defensive Gum of Moringa oleifera for Antibacterial Efficacy Against Resistant Bacterial Species from Human Infections. Pharmaceuticals. 2024; 17(11):1546. https://doi.org/10.3390/ph17111546
Chicago/Turabian StyleAli, Liaqat, Nisar Ahmad, Muhammad Nazir Uddin, Mostafa A. Abdel-Maksoud, Hina Fazal, Sabiha Fatima, Mohamed A. El-Tayeb, Bushra Hafeez Kiani, Wajid Khan, Murad Ali Rahat, and et al. 2024. "Immobilization of Silver Nanoparticles with Defensive Gum of Moringa oleifera for Antibacterial Efficacy Against Resistant Bacterial Species from Human Infections" Pharmaceuticals 17, no. 11: 1546. https://doi.org/10.3390/ph17111546
APA StyleAli, L., Ahmad, N., Uddin, M. N., Abdel-Maksoud, M. A., Fazal, H., Fatima, S., El-Tayeb, M. A., Kiani, B. H., Khan, W., Rahat, M. A., Ali, M., Khan, Y., Rauf, K., Khan, S., Ullah, S., Ahmad, T., Salam, A., & Ahmad, S. (2024). Immobilization of Silver Nanoparticles with Defensive Gum of Moringa oleifera for Antibacterial Efficacy Against Resistant Bacterial Species from Human Infections. Pharmaceuticals, 17(11), 1546. https://doi.org/10.3390/ph17111546

